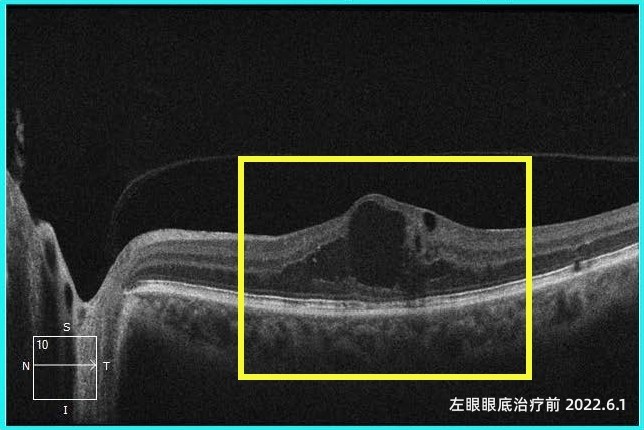

近日,天津普瑞眼科医院为一段长达四年多的跨国医患故事画上了圆满句号。一位来自印度的患者,在医院先后接受了左眼玻璃体腔药物注射术及双眼白内障手术后,视力得到明显改善。
该患者是一位印度教师。四年前左眼视力持续下降,虽然辗转国内外多家医院,却没有很好地得到治疗。后经朋友介绍,慕名来到天津普瑞眼科医院就诊,经系统检查及会诊,眼底病专科李岩院长、李刚主任团队诊断患者为2型左眼黄斑旁毛细血管扩张症( MacTel Ⅱ),这种疾病会导致黄斑中心凹旁毛细血管扩张、微血管瘤形成、血管通透性增加,进而出现黄斑区水肿,严重影响中心视力。经过仔细规划,专家组为患者制定了抗VEGF联合视网膜激光光凝的治疗方案。在连续而系统的诊疗以及不间断的随访后,患者左眼黄斑水肿已经完全消退并长期处于稳定状态。


在眼底病治疗的过程中,患者双眼的白内障问题也日益突出,严重影响了日常生活。天津普瑞眼科医院白内障专科孙堂胜院长团队经过充分评估后,分阶段为其实施了双眼白内障超声乳化联合人工晶体植入术。术后患者双眼视力获得明显提升,对手术效果表示高度满意。在最近一次复查中,患者视力从2022年患病之初时的0.25,提升到如今的0.8。即将告别中国教师生涯时,她表达了对天津普瑞眼科医护技团队的感谢和对未来美好生活的向往,这份跨越山海的国际友情将长久延续下去。

(左眼眼底荧光血管造影显示黄斑区颞侧视网膜毛细血管扩张状态)

此次两位院长及专家团队的联合诊治,不仅彰显了天津普瑞眼科医院多学科协作的高效模式,也体现了医院应对复杂眼病的综合诊疗实力。
天津普瑞眼科医院始终秉持“用爱传递光明”的服务理念,坚持以患者为中心,推动眼底病、白内障、青光眼、小儿眼科、眼表疾病、眼整形与泪道疾病、眼屈视光等亚专科深度交叉融合。未来,医院将继续依托专家团队与国际同步标准的诊疗设备,为更多眼病患者提供高质量、全周期的眼健康诊疗服务。
(免责声明:本文为本网站出于传播商业信息之目的进行转载发布,不代表本网站的观点及立场。本文所涉文、图、音视频等资料之一切权力和法律责任归材料提供方所有和承担。本网站对此咨询文字、图片等所有信息的真实性不作任何保证或承诺,亦不构成任何购买、投资等建议,据此操作者风险自担。)




